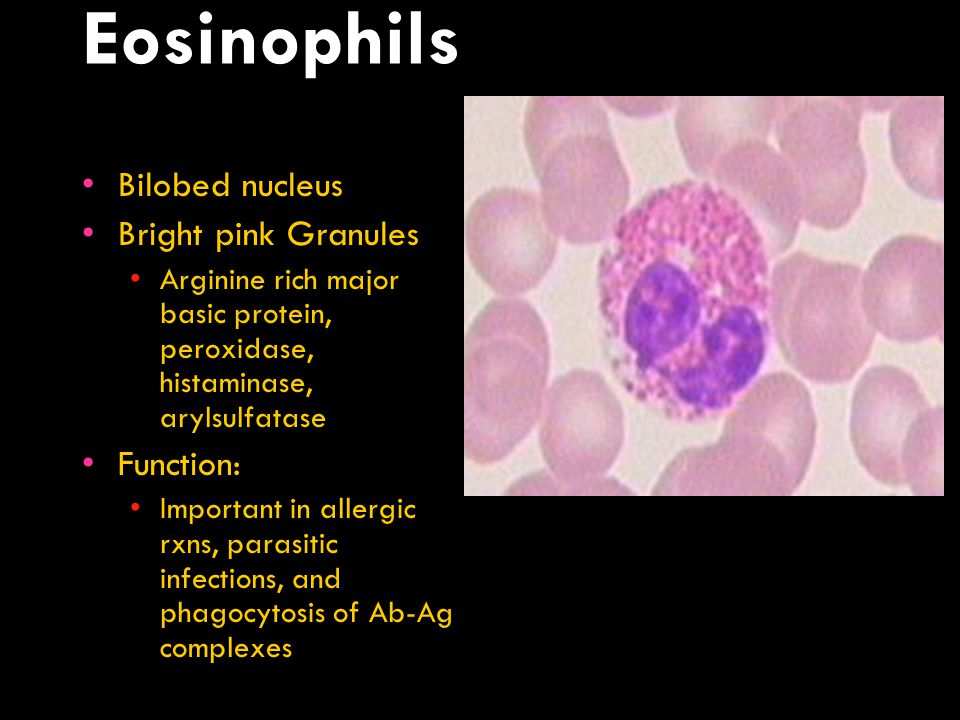

Eozinofillerdeki major bazik protein aşağıdakilerden hangisinden zengindir?
A) Arginin
B) Serin
C) Histidin
D) Lizin
E) Prolin
CEVAP A
Asimetrik dimetilarjinin (ADMA) ve nitrik oksit (NO), etkilerini birlikte gösterirler, bu moleküller arasındaki denge hava yolu tonusunun ve fonksiyonunun sıkı düzenlenmesine katkıda bulunmaktadır
Nitrik oksidin hava yolu aşırı duyarlılığı ve bronşiyal astımın enflamasyonundaki rolü henüz belirlenmemiştir. Bununla birlikte, nitrik oksit sentezlerinin substratı olan L-argininin, bildirildiğine göre parainfluenza virüsünün neden olduğu hava yolu aşırı duyarlılığını hafifletir ve iskemi-reperfüzyonun neden olduğu granülositik enflamasyonu azaltır. L-argininin, hava yolu aşırı duyarlılığı, eozinofilik enflamasyon ve akciğerde interlökin (IL)-5 ekspresyonunu güçlendirir.